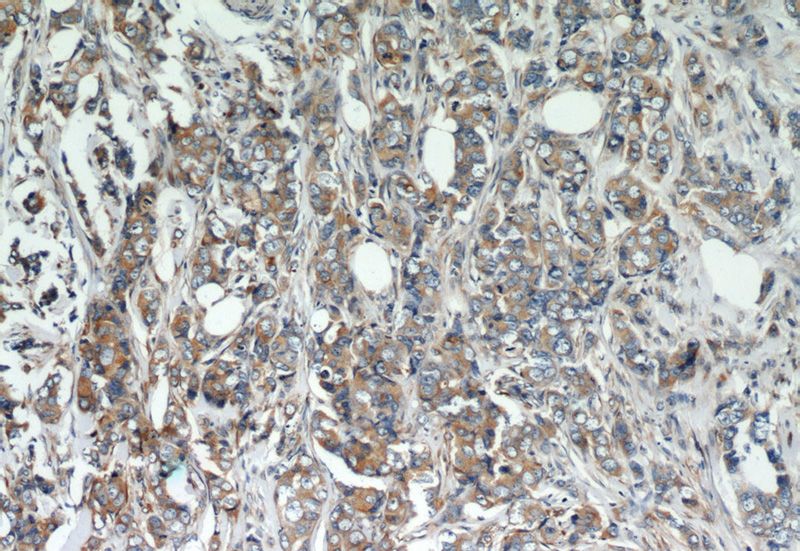
Immunohistochemistry of paraffin-embedded human breast cancer slide using Catalog No:108246(ARF4 Antibody) at dilution of 1:50 (under 10x lens)

-
Product Name
ARF4 antibody
- Documents
-
Description
ARF4 Rabbit Polyclonal antibody. Positive WB detected in mouse brain tissue, HeLa cells, HepG2 cells, human brain tissue, rat brain tissue. Positive IP detected in mouse brain tissue. Positive IHC detected in human breast cancer tissue, human colon cancer tissue. Positive IF detected in HepG2 cells. Positive FC detected in K-562 cells. Observed molecular weight by Western-blot: 21 kDa
-
Tested applications
ELISA, WB, IHC, IP, IF, FC
-
Species reactivity
Human,Mouse,Rat; other species not tested.
-
Alternative names
ADP ribosylation factor 4 antibody; ARF2 antibody; ARF4 antibody
- Immunogen
-
Isotype
Rabbit IgG
-
Preparation
This antibody was obtained by immunization of ARF4 recombinant protein (Accession Number: NM_001660). Purification method: Antigen affinity purified.
-
Clonality
Polyclonal
-
Formulation
PBS with 0.1% sodium azide and 50% glycerol pH 7.3.
-
Storage instructions
Store at -20℃. DO NOT ALIQUOT
-
Applications
Recommended Dilution:
WB: 1:200-1:2000
IP: 1:200-1:2000
IHC: 1:20-1:200
IF: 1:20-1:200
-
Validations

mouse brain tissue were subjected to SDS PAGE followed by western blot with Catalog No:108246(ARF4 Antibody) at dilution of 1:800

IP Result of anti-ARF4 (IP:Catalog No:108246, 3ug; Detection:Catalog No:108246 1:600) with mouse brain tissue lysate 5200ug.

Immunofluorescent analysis of HepG2 cells using Catalog No:108246(ARF4 Antibody) at dilution of 1:50 and Alexa Fluor 488-congugated AffiniPure Goat Anti-Rabbit IgG(H+L)
Immunohistochemistry of paraffin-embedded human breast cancer slide using Catalog No:108246(ARF4 Antibody) at dilution of 1:50 (under 10x lens)

Immunohistochemistry of paraffin-embedded human breast cancer slide using Catalog No:108246(ARF4 Antibody) at dilution of 1:50 (under 40x lens)

1X10^6 K-562 cells were stained with 0.2ug ARF4 antibody (Catalog No:108246, red) and control antibody (blue). Fixed with 90% MeOH blocked with 3% BSA (30 min). Alexa Fluor 488-congugated AffiniPure Goat Anti-Rabbit IgG(H+L) with dilution 1:1000.
-
Background
ARF4, also named as ARF2, belongs to the small GTPase superfamily and Arf family. ADP-ribosylation factors (ARFs) are members of the ARF family of GTP-binding proteins of the Ras superfamily, with 20 kDa protein size. ARFs bind and regulate GTP/GDP cycle by alternating between the active GTP-bound and inactive GDP-bound conformations. ARF family proteins are essential and ubiquitous in eukaryotes. Six highly conserved members of the family have been identified in mammalian cells. They function in vesicular traffic and actin remodelling and other bioprocesses in cells. ARF4 and ARF5 are class II ARFs. Their function are not fully described. (PMID: 7759471, PMID: 16042562). This antibody can bind ARFs for the close sequences.
-
References
- Kudelko M, Brault JB, Kwok K. Class II ADP-ribosylation factors are required for efficient secretion of dengue viruses. The Journal of biological chemistry. 287(1):767-77. 2012.
- Takashima K, Saitoh A, Hirose S. GBF1-Arf-COPI-ArfGAP-mediated Golgi-to-ER transport involved in regulation of lipid homeostasis. Cell structure and function. 36(2):223-35. 2011.
- Jain S, Yoon SY, Zhu L. Arf4 determines dentate gyrus-mediated pattern separation by regulating dendritic spine development. PloS one. 7(9):e46340. 2012.
- Pasetto M, Antignani A, Ormanoglu P. Whole-genome RNAi screen highlights components of the endoplasmic reticulum/Golgi as a source of resistance to immunotoxin-mediated cytotoxicity. Proceedings of the National Academy of Sciences of the United States of America. 112(10):E1135-42. 2015.
- Iglesias NG, Mondotte JA, Byk LA. Dengue Virus Uses a Non-Canonical Function of the Host GBF1-Arf-COPI System for Capsid Protein Accumulation on Lipid Droplets. Traffic (Copenhagen, Denmark). 16(9):962-77. 2015.
- Hanai A, Ohgi M, Yagi C, Ueda T, Shin HW, Nakayama K. Class I Arfs (Arf1 and Arf3) and Arf6 are localized to the Flemming body and play important roles in cytokinesis. Journal of biochemistry. 159(2):201-8. 2016.
- Münzberg C, Höhn K, Krndija D. IGF-1 drives chromogranin A secretion via activation of Arf1 in human neuroendocrine tumour cells. Journal of cellular and molecular medicine. 19(5):948-59. 2015.
- Li MY, Grandadam M, Kwok K. KDEL Receptors Assist Dengue Virus Exit from the Endoplasmic Reticulum. Cell reports. 2015.
Related Products / Services
Please note: All products are "FOR RESEARCH USE ONLY AND ARE NOT INTENDED FOR DIAGNOSTIC OR THERAPEUTIC USE"
